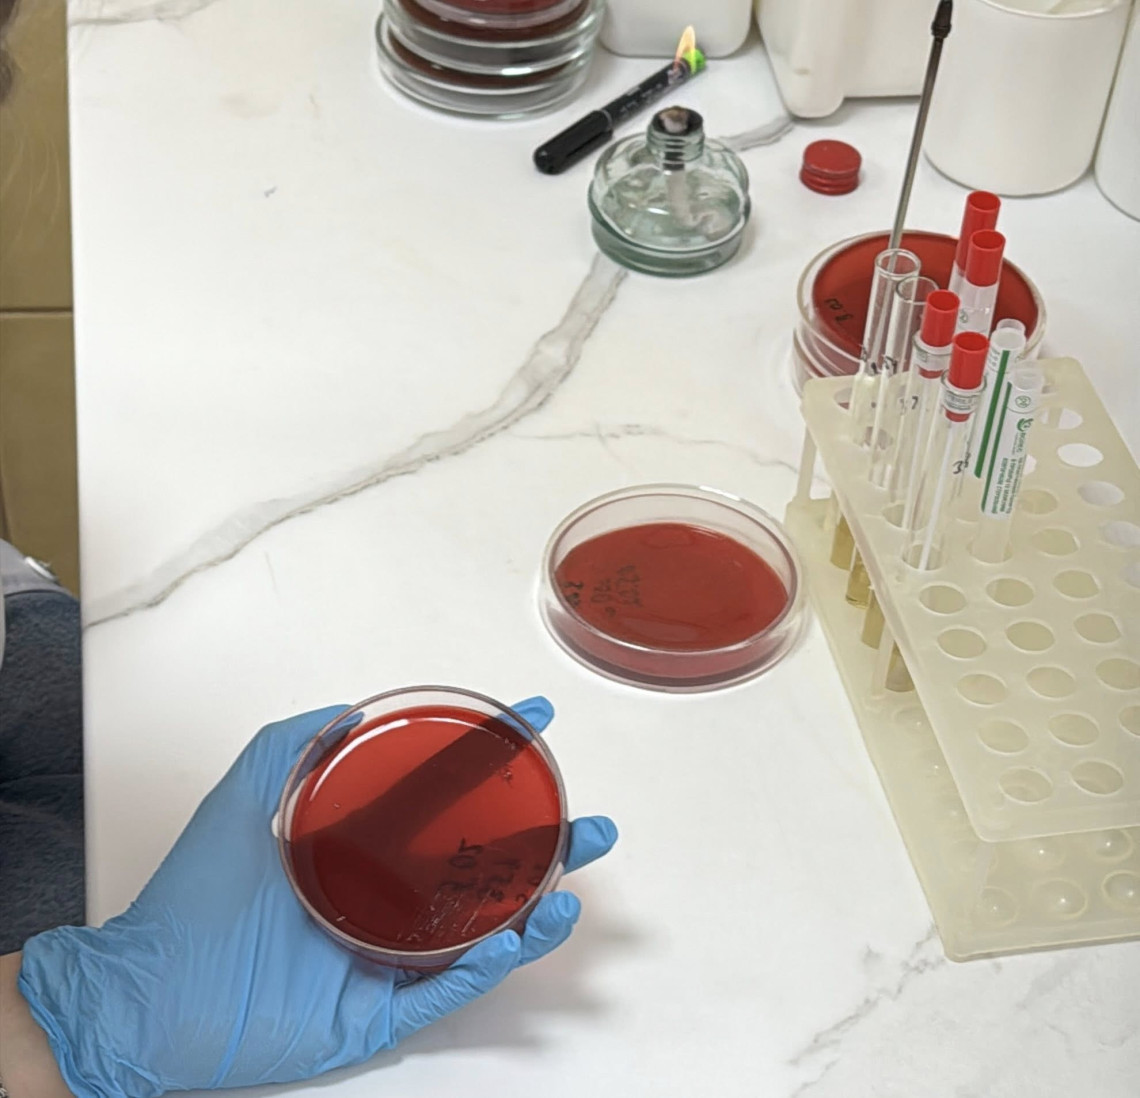

СТУДЕНТИ-ЛАБОРАНТИ ОПАНОВУЮТЬ ПРАКТИКУ
Практика — це той момент, коли знання з підручників оживають. Студенти 3 курсу Рівненської медичної академії, спеціальності «Лабораторна діагностика», зробили ще один важливий крок до своєї професії. За мікроскопами, аналізаторами, серед пробірок і реактивів вони вчилися головному — відповідальності за кожен результат, уважності до деталей і повазі до праці, від якої часто залежить людське життя.
Це були дні зосередженості, хвилювання і маленьких професійних перемог. Саме тут опановували навички забору крові, виконували бактеріологічний посів мазка на поживне середовище. А також проводили дослідження зразків крові на гематологічному аналізаторі для визначення основних показників. Визначали вміст білка методом додавання реактиву та проводили визначення глюкози в сечі. І це далеко не все…
Попереду ще багато викликів, але цей досвід уже став міцним фундаментом майбутнього фаху наших лаборантів.